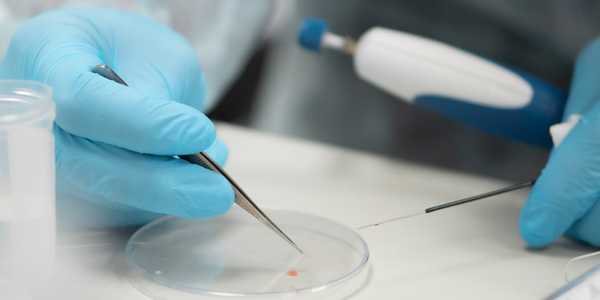

Режимы проведения химиотерапии рака - амбулаторый, стационарный
Добавил пользователь Skiper Обновлено: 21.11.2025
Лекарственная противоопухолевая терапия, в том числе и химиотерапия, - один из основных методов лечения рака. При химиотерапии в человеческий организм вводятся различные токсические вещества, которые губительно воздействуют на клетки злокачественных опухолей. Важно при этом, чтобы яды и токсины оказывали наименьшее отрицательное воздействие на весь организм больного.
Схемы химиотерапевтического лечения регламентируются международными методиками и правилами, и рассчитываются индивидуально. Врач-химиотерапевт подбирает пациенту лечение, руководствуясь различными критериями, среди которых:
- морфологическая форма рака
- распространённость процесса
- возраст пациента
- наличие сопутствующих заболеваний и так далее.
Процедура представляет собой внутривенное введение химиопрепаратов или приём таблеток и капсул. Чаще всего терапия назначается несколькими циклами и должна повторяться через определённый промежуток времени - это связано с клеточным циклом.


Виды химиотерапии
- монохимиотерапия — лечение одним препаратом;
- полихимиотерапия — лечение несколькими препаратами одновременно.
Сложные комбинации из нескольких химиопрепаратов на сегодняшний день используются чаще, так как они более эффективные.

Химиотерапия нередко применяется как часть комбинированного лечения рака:
- неоадъюватная — проводится до радикального лечения;
- адъювантная — назначается после хирургической операции.
Дозы и режимы применения противоопухолевых препаратов
Противоопухолевые лекарственные препараты и их дозировка подбираются строго индивидуально.
У каждого препарата имеются свои характеристики и особенности. При проведении химиотерапии важными являются следующие параметры:
- доза препарата
- режим и методика его введения
- интервал между введениями
- осложнения на фоне его применения.


Дозу препарата рассчитывают исходя из схемы химиотерапии, роста, веса, возраста, состояния больного, а в некоторых случаях, на основании лабораторных показателей пациента.
Режимы
Если необходимо повысить интенсивность химиотерапии, то увеличивают дозу препарата, это так называемая высокодозная терапия, либо сокращают интервал между курсами ХТ, то есть вводят уплотненные режимы.
Также существуют метрономные режимы применения цитостатических препаратов, когда вводятся малые дозы препаратов, но постоянно в течение длительного времени.
После каждого курса химитерапевтического лечения обязательно делается определенный перерыв для восстановления организма. Как правило, повторные курсы ХТ проводят через каждые три-четыре недели, это период, в течение которого восстанавливаются показатели лейкоцитов, тромбоцитов и пр.
При использовании некоторых химиопрепаратов, к примеру, нитрозопроизводных, этот интервал увеличивается до 6 недель.
Продолжительность лечения и количество курсов химиотерапии зависит от вида опухоли, от особенностей течения болезни от того, как организм реагирует на лечение. Иногда возникает необходимость прекратить или изменить лечение, и это решение принимает лечащий врач.

Способы применения химиопрепаратов
- Системная химиотерапия
Препараты вводятся внутрь (через рот), подкожно, внутривенно, внутримышечно, ректально.
Системная химиотерапия подразумевает воздействие на весь организм. - Регионарная химиотерапия
Подразумевается воздействие цитостатического препарата в повышенных концентрациях на опухолевую массу с ограничением его поступления в другие органы путем введения в сосуды, питающие новообразование (например, при меланоме). - Локальная химиотерапия
Препараты в виде мазей или растворов наносят на поверхностные опухолевые очаги (кожные язвы), вводят в серозные полости (асцит, плеврит), спинномозговой канал (интратекально) при поражении мозговых оболочек и внутрипузырно - при новообразованиях мочевого пузыря.
Правила введения противоопухолевых препаратов
Наиболее широко используется внутривенное введение противоопухолевых средств. При этом врач обязательно учитывает индивидуальные особенности вен пациентов.
- введение противоопухолевых препаратов должно выполняться только в отделениях, специализирующихся в цитотоксической химиотерапии;
- медицинские сестры для выполнению работ с цитостатиками должны пройти специальную подготовку;
- необходимо соблюдать последовательность и скорость введения препаратов, учитывать химические свойства препаратов при использовании оборудования для их введения;
- соблюдать правила и сроки хранения препаратов, как в аптечной упаковке, так и после их приготовления;
- нельзя смешивать препараты «в одном флаконе», если в инструкции по применению данных препаратов нет для этого особых указаний.
- приготовление инъекционных растворов должно выполняться в стерильном боксе;
- иглы, шприцы, флаконы, ампулы и остатки неиспользованных препаратов должны уничтожаться;
- для инфузии химиотерапевтических препаратов, обладающих кожно-нарывным действием, не должны использоваться иглы типа «бабочка»; предпочтительнее использование периферических катетеров типа «браунюля»;
- для препаратов кожно-нарывного действия с длительным периодом инфузии (12 часов и более) предпочтительнее использовать центральный венозный доступ — установка порт-системы.



Имплантируемые порт-системы
Имплантируемая порт-система — это катетер, установленный в сосуд или полость и соединенный с ним резервуар-камера. Система «порт — катетер» широко используется в медицине уже более чем 30 лет.
Порт-системы помогают проходить лечение более эффективно, безопасно и качественно. Особенно актуальна их установка в качестве устройства сосудистого доступа пациентам, которым назначено длительное лечение, при осложнениях на фоне химиотерапии, которые привели к затруднению венозного доступа.
При этом терапию пациент может получать как в условиях стационара, так и амбулаторно.
Инфузия лекарственных препаратов производится с помощью специальных игл типа Губера, которые, пунктируя силиконовую мембрану порта, позволяют вводить инфузионный раствор в резервуар, не повреждая силиконовую мембрану. Далее препарат попадает через катетер в кровоток или полость, в зависимости от вида порт-системы и места расположения катетера.
Порт- система полностью скрыта под кожей. Поэтому она подходит для длительного использования, не обременяет пациента и не мешает проведению гигиенических процедур. Необходимо помнить, что при отсутствии использования порт-систему необходимо промывать как минимум 1 раз в 2 месяца.


Подготовка к химиотерапии
Химиотерапия - это лечение ядами, поэтому врач перед проведением терапии требует выполнить большой список анализов и обследований для мониторинга функционирования различных органов и выбора схемы лечения. Желательно еще до начала химиотерапии пройти курс лечения всех хронических очагов инфекции: кариеса, хронического гастрита и прочих.
Чтобы не было проблем с поиском вен и установкой катетера за день до химиотерапии желательно выпить 1,5-2 литра жидкости.
Для тренировки вен рекомендуется периодически сжимать кистевой эспандер по 10 мин 3 раза в день или до усталости. При этом рука должна быть свешена ниже уровня сердца.
В день проведения ХТ нужно держать руки в тепле, возможно применение теплых обертываний на места инъекций. Можно периодически обрабатывать руки теплыми полотенцами.
Во время прохождения химиотерапии
В день химиотерапии, с утра необходимо позавтракать.
Далее необходимо соблюдать несколько несложных правил:

Об осложнениях после химиотерапии читайте здесь.
Возможно ли повысить эффективность химиотерапии?
Поиск основных направлений повышения эффективности терапии опухолей осуществляется в разных направлениях:
- разработка препаратов нового типа, в частности таргетной терапии, избирательно действующих на опухолевые клетки;
- разработка комбинированного применения двух и более препаратов — полихимиотерапии;
- совершенствование химиотерапии как этапа комбинированного лечения опухолей;
- применение иных лекарств для уменьшения побочного действия химиотерапии;
- доработка методик применения препаратов — дозирования, режима.


Авторская публикация:
ЯНЧИЙ МАРИНА НИКОЛАЕВНА
врач-онколог отделения краткосрочной химиотерапии
НМИЦ онкологии им Н.Н. Петрова Минздрава России
Что вам необходимо сделать
Если вы хотите узнать побольше о бесплатных возможностях ФБГУ НМИЦ онкологии им. Н.Н. Петрова Минздрава России, получить очную или заочную консультацию по диагностике и лечению, записаться на приём, ознакомьтесь с информацией на официальном сайте.
Если вы хотите общаться с нами через социальные сети, обратите внимание на аккаунты в ВКонтакте и Одноклассники.
Химиотерапия
Химиотерапия - метод лекарственного лечения рака с помощью клеточных ядов (цитостатических препаратов). То, что клеточные яды могут замедлять развитие опухолей, стало известно в середине прошлого века.

В 1919 году ученые обнаружили, что отравляющее вещество иприт угнетает созревание кровяных клеток. В 1942 году на основе иприта синтезировали эмбихин, который в 1946 году впервые применили в лечении рака. Уже в 1947 году его стали применять в НИИ онкологии (ныне НМИЦ онкологии им Н.Н.Петрова). Препарат вводился пациентам с лимфомой Ходжкина и позволял добиться выраженного улучшения. В то же время он и отравлял здоровые клетки.
В 1940- х годах был синтезирован метотрексат. Ученые исследовали его влияние при остром лимфобластном лейкозе у детей. И именно эти исследования стали первым шагом в химиотерапии опухолевых заболеваний. Метотрексат и по сей день используется при ряде опухолевых заболеваний, в основном - заболеваний крови.
Химиотерапия принципиально отличается от хирургического лечения и лучевой терапии. Она позволяет воздействовать одновременно на все опухолевые клетки в организме. Поэтому химиотерапию (и другие варианты лекарственной противоопухолевой терапии) называют системной терапией.
Как работает химиотерапия
Химиотерапевтические препараты (цитостатики) - это клеточный яд. Этот яд прерывает рост и деление опухолевых клеток. Конечно, н нормальные клетки подвергаются воздействию яда, но не так сильно. Именно клетки опухоли - из-за высокой скорости их деления - наиболее уязвимы для химиотерапии.
Чем химиотерапия отличается от других видов лечения
В лечении рака применяются различные варианты лечения. В чем особенности химиотерапии?
а) Механизм воздействия в сравнении с другими методами:
- химиотерапия действует неизбирательно. Она нарушаетобщие механизмы функционирования и в нормальных, и в опухолевых клетках. Но на злокачественные клетки она влияет сильнее из-за высокой скорости их роста.
- таргетная терапия “выключает” отдельный молекулярный процесс в опухоли, который и заставляетконкретную опухоль расти и давать метастазы. Таргетная терапия в меньшей степени затрагивает процессы функционирования в нормальных клетках
- иммунотерапия заставляетиммунную систему бить по опухоли. Химиотерапия напрямую уничтожаетопухолевые клетки, не привлекая для этого иммунную систему.
б) Побочные эффекты. Из-за разных механизмов действия побочные эффекты химиотерапии, таргетной и иммунотерапии тоже различаются. Подробнее об этом читайте в статьях:
Какие разновидности химиотерапии бывают
а) По целям химиотерапии ее разделяют на:
- предоперационную (неоадъювантную);
- послеоперационную (адъювантную);
- поддерживающую (паллиативную), в том числе, симптоматическую.
б) По группам химиотерапевтических препаратов выделяют:
- алкилирующие агенты (доксорубицин, темозоломид, циклофосфамид, ифосфамид) и препараты платины (цисплатин, карбоплатин, оксалиплатин). Они грубо повреждают генетический аппарат (ДНК) опухолевых клеток, что приводит к их гибели.
- “блокаторы” микротрубочек (паклитаксел, доцетаксел, эрибулин, винорельбин). Они “ломают” веревки, которые разделяют опухолевую клетку на две при ее попытке поделиться и удвоиться.
- антиметаболиты (метотрексат, фторурацил, гемцитабин). Эти вещества“обманывают” опухолевую клетку, выдавая себя за полезные для нее вещества. На самом деле нарушают ключевые процессы обмена веществ в опухоли.
- “выключатели” топоизомеразы (топотекан, иринотекан, этопозид). Превращают ДНК опухолевых клеток в клубок грязи, неспособный к нормальному функционированию.
Что такое схемы химиотерапии
Схема химиотерапии - комбинация химиотерапевтических препаратов, которая применяется при конкретном опухолевом заболевании (с учетом стадии, гистологической формы, молекулярно-генетических особенностей).
В схемы обычно входят препараты с разным механизмом противоопухолевого эффекта. Так достигается воздействие на большее количество клеток конкретной опухоли. Для лечения применяются только те схемы препаратов, которые показали свою эффективность при конкретном варианте заболевания в исследованиях.
- доксорубицин + циклофосфамид (“красная химия”) - предоперационная химиотерапия при раке молочной железы;
- карбоплатин + этопозид при лечении метастатического мелкоклеточного рака легкого.
Химиотерапия может сочетаться с другими видами лекарственного противоопухолевого лечения:
- с иммунотерапией (пембролизумаб + паклитаксел/карбоплатин приплоскоклеточном раке легкого; карбоплатин/этопозид + атезолизумаб примелкоклеточном раке легкого)
- с таргетной терапией (трастузумаб + пертузумаб + доцетаксел приHER2-положительном раке молочной железы.
Как долго проводится химиотерапия
В зависимости от вида опухолевого заболевания и целей лекарственного лечения химиотерапия может проводиться в течение нескольких месяцев (предоперационная, послеоперационная химиотерапия) или на постоянной основе (поддерживающая химиотерапия при метастатическом раке).
При метастатическом раке химиотерапия обычно проводится до того момента, пока она не перестанет “работать” (т.е. заболевание прогрессирует, опухоль продолжает распространяться). Также терапия прерывается, когда становится непереносимой для пациента из-за своей токсичности. В этих случаях схема лекарственного лечения меняется лечащим врачом.
Кому и когда показана химиотерапия
Химиотерапия может быть показана практически всем пациентам со злокачественными новообразованиями в том или ином виде. В зависимости от типа опухоли и ее стадии может быть назначена как предоперационная/послеоперационная химиотерапия, так и поддерживающая химиотерапия.
- в качестве предоперационной терапии: доксорубицин + циклофосфамид; трастузумаб + пертузумаб + доцетаксел + карбоплатин при раке молочной железы.
- в качестве послеоперационной терапии (примеры - схема FOLFOX (оксалиплатин + фторурацил + лейковорин) при третьей стадии рака толстой кишки.
- в качестве поддерживающей (паллиативной) химиотерапии (примеры - доцетаксел при метастатическом раке предстательной железы).
Где проводится химиотерапия и какие врачи ее проводят

Назначением и проведением химиотерапии занимаются врачи-онкологи, специализирующиеся на ее проведении: медицинские онкологи или “химиотерапевты”.
Химиотерапия может проводиться как в амбулаторных, так и в стационарных условиях. То, в каких условиях проводится химиотерапия, определяется конкретной схемой и характером ожидаемых побочных явлений.
В амбулаторных условиях химиотерапия проводится:
- в центрах амбулаторной онкологической помощи (ЦАОП). ЦАОП может быть организованна базе поликлиники, центральной районной больницы, многофункционального медицинского центра, онкодиспансера;
- в отделениях дневного стационара многопрофильного медицинского центра, онкологической больницы или онкодиспансера.
В стационарных условиях химиотерапия проводится в соответствующих отделениях в онкологических стационарах.
Условия проведения химиотерапии определяются врачом, исходя из:
- выбранной схемы химиотерапии;
- длительности ее введения;
- характера опухолевого заболевания;
- состояния пациента;
- организационных возможностей учреждения.
Как проводится химиотерапия
Различные схемы химиотерапии имеют свои особенности. Само проведение химиотерапии чаще всего можно поделить на два условных этапа:
а) Сопроводительная терапия (подготовительная терапия, премедикация) - введение препаратов, направленных на профилактику возникновения нежелательных явлений при химиотерапии и после нее.
В рамках сопроводительной терапии могут применяться препараты, профилактирующие тошноту (ондансетрон, фосапрепитант/апрепитант, дексаметазон), нежелательные реакции при введении препаратов (атропин перед иринотеканом для профилактики холинергического криза, дексаметазон перед паклитакселом/доцетакселом для профилактики инфузионных реакций), а также инфузионная терапия в виде большого количества жидкости - с целью профилактики повреждения почек (цисплатин).
Ряд схем, применяющихся в рамках лечения онкогематологических заболеваний, требует профилактического применения противомикробных препаратов - из-за наиболее высокого риска возникновения инфекционных осложнений.
б) Непосредственное введение противоопухолевых препаратов в рамках конкретной схемы химиотерапии. У каждой схемы существуют свои особенности введения. Они могут различаться:
- по времени, необходимому на безопасное введение препаратов;
- по характеру возможных нежелательных реакций, которые могут возникать при непосредственном введении препаратов или в последующие часы.
Существуют схемы, которые проводятся в течении двух и более дней.
- FOLFOX при раке толстой кишки и желудка;
- VAC/IE при саркоме Юинга;
- AI при саркомах мягких тканей;
- карбоплатин - этопозид при мелкоклеточном раке легкого;
- CHOP при лимфомах.
Из-за возможных нежелательных явлений они подразумевают проведение большого объема сопроводительной терапии и необходимости круглосуточного стационарного наблюдения в период введения препаратов.
В то же время существует ряд схем, токсичность которых может хорошо контролироваться в амбулаторных условиях. При этих схемах введение препаратов занимает всего несколько часов (доксорубицин + циклофосфамид; паклитаксел) или в их состав входят препараты в таблетках (капецитабин). Такие виды химиотерапии могут проводиться как в амбулаторных условиях (дневной стационар), так и условиях круглосуточного стационара.
Химиотерапия при колоректальном раке
При колоректальном раке химиотерапия может использоваться как основной метод лечения или сочетаться с другими видами терапии. Ее роль зависит от стадии заболевания и расположения опухоли: в толстой или прямой кишке.
Если у пациента рак толстой кишки и нет метастазов во внутренних органах, костях, основная цель лечения — полностью избавиться от опухолевых клеток. Тогда химиотерапию назначают только после операции (до операции химиотерапия не используется). Она направлена на уничтожение оставшихся после хирургического лечения опухолевых клеток, которые не видны ни глазом, ни на КТ или МРТ. Как правило, химиотерапию назначают при III стадии, когда опухолевые клетки обнаруживаются в удаленных лимфоузлах. Действие химиотерапии в такой ситуации направлено на то, чтобы снизить риск возврата болезни (рецидива).
При II стадии заболевания послеоперационную химиотерапию могут назначить , если у пациента есть факторы риска. Их определяет лечащий врач.
При I стадии лечение ограничивается операцией.
Если у пациента рак прямой кишки и нет метастазов, химиотерапию могут назначить перед операцией, чаще в комбинации с лучевой терапией. Ее основная цель в таком случае — уменьшить размер опухоли и улучшить результаты операции. Если на первом этапе проводится операция, то химиолучевая терапия может быть назначена после нее.
Если химиотерапию проводят перед операцией или после нее, она обычно длится от 3 до 6 месяцев. Время зависит от конкретного режима и факторов риска.
Если у пациента IV стадия колоректального рака (есть метастазы), химиотерапия является основным методом лечения. Иногда ее назначают перед операцией по удалению метастазов из печени.
Химиотерапия действует системно и через кровеносную систему достигает большинства органов и клеток организма. Ее эффект направлен на предотвращение дальнейшего развития болезни: роста опухоли, появления новых метастазов. Еще один эффект химиотерапии — уменьшение симптомов заболевания. В такой ситуации химиотерапия часто сочетается с таргетной терапией, что еще больше снижает риск прогрессирования и рецидива.
Лекарственное лечение в случае IV стадии обычно продолжают, пока не случится:
- Прогрессирование заболевания — ситуация, когда по результатам КТ или МРТ становится понятно, что опухоль перестает реагировать на химиотерапию. Например, опухоль или метастазы продолжают расти или появляются новые метастазы. В таком случае назначают другие химиопрепараты (часто вместе с таргетными), то есть переходят на следующую линию лечения.
- Непереносимая токсичность — ситуация, когда вред от химиотерапии (то есть побочные эффекты) перевешивает потенциальную пользу от нее. В таком случае либо уменьшают дозу химиопрепаратов, либо меняют их на менее токсичные (но часто они менее эффективны). Иногда химиотерапию отменяют вовсе.
Какие лекарства используются?
При химиотерапии колоректального рака используют определенные группы препаратов. Их популярность у врачей-онкологов связана с хорошей эффективностью и не очень тяжелыми побочными эффектами. Как после операции, так и при метастатической стадии чаще всего используются препараты из группы фторпиримидинов (5-фторурацил, капецитабин), а также препараты платины (оксалиплатин). Они входят в комбинированные режимы FOLFOX (ФОЛФОКС) и XELOX (КСЕЛОКС), состоящие из двух химиопрепаратов.
При метастатической стадии также могут назначать иринотекан в сочетании с оксалиплатином (режим FOLFIRI) или так называемый «триплет» — режим, состоящий из 5-фторурацила, оксалиплатина и иринотекана (FOLFOXIRI).
Если у пациента есть метастазы, химиопрепараты часто сочетают с таргетной терапией. Это такие препараты, как бевацизумаб, цетуксимаб/панитумумаб, афлиберцепт, регорафениб. Таргетные препараты назначают в зависимости от мутаций, которые есть в опухоли. В сочетании с химиотерапией они улучшают результаты выживаемости.
Способы введения препаратов
Обычно химиотерапевтические препараты — это растворы для внутривенного введения. Лекарство разводят на физиологическом растворе или глюкозе и вводят внутривенно капельно в стационаре или в кабинете амбулаторной химиотерапии под контролем медицинского персонала. Введение занимает от нескольких минут (медленное струйное введение) до нескольких часов. Часто используются помпы для длительных введений, которые могут занимать до 46 часов. Помпа располагается в специальной сумке-переноске, которую удобно носить с собой. Введение препарата происходит автоматически с низкой скоростью.
Химиотерапию можно вводить через периферический венозный катетер (в вены на руке) или через центральный, который устанавливается в более крупные вены с толстыми стенками (ЦВК, порт-система, пик-катетер). В таком случае снижается риск экстравазации (выхода химиопрепарата из вены в окружающие ткани) и связанных с этим побочных эффектов. Подробнее - в статье "Способы введения препаратов". Существуют также таблетированные формы химиопрепаратов. Их нужно принимать ежедневно в течение нескольких дней на протяжении цикла. Принимать таблетированные формы пациент может самостоятельно в домашних условиях.
Как понять, какая терапия лучше?
Выбор конкретного режима химиотерапии зависит от многих факторов, например:
- стадии заболевания,
- мутаций, которые произошли в опухоли,
- режимов химиотерапии, которые назначались в прошлом,
- сопутствующих заболеваний,
- предпочтений пациента.
Схему химиотерапии выбирает лечащий врач, который в каждом конкретном случае оценивает всю информацию о пациенте и особенностях конкретной опухоли. Учитывают также данные клинических рекомендаций и клинических исследований.
Таблетки vs капельницы: что лучше?

В России у 3 762 218 человек диагностированы злокачественные новообразования и каждый год эта цифра увеличивается более чем на 600 000 новых случаев [1]. Всем онкопациентам необходимо противоопухолевое лечение, и многим из них - лекарственное.
Большую часть лекарственного противоопухолевого лечения пациенты, как правило, получают с помощью внутривенных инъекций. Это предполагает регулярное посещение онкологического учреждения для проведения очередного цикла терапии. Нередко это приносит неудобства, а инъекции могут быть болезненными. В некоторых случаях количество циклов не ограничено определенным числом, лечение может длиться месяцы или годы, вплоть до прогрессирования или развития непереносимой токсичности [2].
Чтобы пациент мог сократить количество визитов в больницу, все больше новых препаратов производится в пероральной форме.
Что такое пероральная лекарственная противоопухолевая терапия?
- Пероральная терапия - это любая терапия, которая принимается внутрь через рот в виде таблеток или капсул.
Безусловно такое лечение позволяет человеку вести активную жизнь и работать, что особенно актуально при длительной противоопухолевой терапии.
Таблетки - это только химиотерапия?
Не только. Ниже представлены основные препараты, которые можно использовать внутрь перорально:
- Химиотерапия: циклофосфамид, метотрексат, этопозид, капецитабин, винорелбин;
- Гормонотерапия: тамоксифен, торемифен, анастрозол, летрозол, эксеместан, мегестрол, медроксипрогестерон, бикалутамиб, энзалутамид, абиратерон;
- Таргетная терапия: регорафениб, сорафениб, сунитиниб, пазопаниб, акситиниб, гефитиниб, эрлотиниб, афатиниб, осимертиниб, кризотиниб, олапариб, палбоциклиб, рибоциклиб, лапатиниб, дабрафениб, траметиниб, вемурафениб, кобиметиниб.
Почему мне выписали таблетки, а моей знакомой с таким же диагнозом — капельницы?
Если вам назначили таблетки — это не значит, что исчерпаны все возможности вашего лечения.
Таблетки или капсулы могут назначаться как самостоятельное лечение, так и в качестве послеоперационного (после радикального удаления опухоли) профилактического (адъювантного) лечения. Пример таблетированной адъювантной терапии при раке молочной железы - тамоксифен или анастрозол в течение 5 лет [3].

В каких случаях могут назначить «химию» в таблетках?
Таблетки или капсулы назначают по определенным показаниям:
- Гистологический тип опухоли. Например, аденокарцинома.
- Рецепторный статус опухоли. Например, наличие рецепторов к эстрогену и прогестерону [3].
- Другие характеристики опухоли. Например, наличие определенной мутации, степень злокачественности, стадия распространения, наличие лимфоваскулярной инвазии и т.д.
- Важно и состояние вашего желудочно-кишечного тракта, а именно — возможность усвоить и произвести всасывание лекарственного препарата в системный кровоток.
Таблетки также могут применяться в следующих случаях:
- Пораженные вены;
- Невозможность внутривенного введения;
- Отек верхних конечностей;
- Поражение кожи грудной стенки, когда нет возможности установить порт-систему.
Например, пациенту может быть назначена поддерживающая лечебная химиотерапия капецитабином вместо внутривенного 5-фторурацила с лейковорином [4].
При опухолях каких органов могут назначить таблетки?
Рак молочной железы [5]:
- Химиотерапия (метастатический процесс): CMF (циклофосфамид внутрь + метотрексат в/в + 5-фторурацил в/в); Метрономный режим циклофосфамид + метотрексат; Капецитабин; Винорелбин (капсулы); Этопозид (капсулы).
- Гормонотерапия (послеоперационно или при метастатическом процессе): Тамоксифен, Анастрозол, Летрозол, Эксеместан, Мегестрол.
- Таргетная терапия (метастатический процесс): Рибоциклиб, Палбоциклиб, Лапатиниб.
- Остеомодифицирующий агент (при метастазах в костях): Клодроновая кислота.
Рак ободочной и прямой кишки [6,7]:
- Химиотерапия (послеоперационно или при метастатическом процессе): в схеме CapOX (XELOX) - Капецитабин внутрь + Оксалиплатин внутривенно, Капецитабин.
- Таргетная терапия (при метастатическом процессе): Регорафениб.
Рак яичников [8]:
- Химиотерапия (метастатический процесс): этопозид; циклофосфамид + метотрексат (метрономный режим).
- Гормонотерапия (метастатический процесс): летрозол, анастрозол, тамоксифен.
- Таргетная терапия (метастатический процесс или рецидив): Олапариб.
Рак тела матки (метастатический процесс) [9]: гормонотерапия (летрозол, анастрозол, тамоксифен).
Рак шейки матки (метастатический процесс) [10]: капецитабин.
Немелкоклеточный рак легкого (метастатический процесс) [11]: Гефитиниб, Эрлотиниб, Афатиниб, Осимертиниб, Кризотиниб.
Почечно-клеточный рак (метастатический процесс) [12]: Сорафениб, Сунитиниб, Пазопаниб и Акситиниб.
Меланома кожи (послеоперационно или при метастатическом процессе) [13]: Дабрафениб, Траметиниб, Вемурафениб, Кобиметиниб.

Меньше ли осложнений от таблеток или капсул?
Нет, таблетки и капсулы — это все равно противоопухолевая терапия. Она отличается лишь способом доставки лекарственного средства в организм. Осложнения и побочные эффекты такие же, как и при инъекциях.
Потеряю ли я волосы от противоопухолевой лекарственной терапии в таблетках?
Да, в некоторых случая это возможно [14], например:
- Этопозид вызывает обратимую алопецию у 8-66% пациентов, а иногда вызывает полную потерю волос;
- Метотрексат, Винорелбин и Циклофосфамид часто вызывают умеренную алопецию;
- Капецитабин редко вызывает выпадение волос.
Будет ли тошнота и рвота при пероральной противоопухолевой лекарственной терапии?
Да, некоторые препараты больше других вызывают рвоту [15]:
- Для Циклофосфамида, Винорелбина и Кризотиниба характерна умеренная эметогенность, т.е. рвота возникает у 30-90% пациентов. Для профилактики обязательно назначается противорвотная терапия.
- Капецитабин, этопозид и большинство таргетных препаратов относятся к препаратам с низкой эметогенностю, т.е. рвота возникает у 10-30% пациентов
- Метотрексат и Вемурафениб обладают минимальной эметогенностью (рвота у <10%) и не требуют назначения противорвотных средств.
- Еще реже вызывает рвоту гормональная терапия.
Какие еще осложнения возможны при приеме противоопухолевой терапии в таблетках и капсулах?
- Изменения со стороны крови: анемия, лейкопения, нейтропения, тромбоцитопения;
- Изменения кожи (капецитабин - ладонно-подошвенный синдром [16]; регорафениб, сорафениб, сунитиниб и акситиниб - ладонно-подошвенная кожная реакция [17]);
- Стоматит;
- Слабость;
- Диарея;
- Дисменорея, приливы, вагинальное кровотечение (гормональная терапия [18]).
О чем мне стоит знать до начала пероральной противоопухолевой лекарственной терапии?
- В каких дозах и когда принимать (сколько раз в день; после, до или во время еды);
- Сопутствующие мероприятия (пить много жидкости до, во время и после приема циклофосфамида [19]; с какими продуктами совместимо);
- Обязательно сообщить врачу, какие препараты вы принимаете по сопутствующим заболеваниям (артериальная гипертензия, сахарный диабет и т.д.), чтобы предусмотреть возможные взаимодействия;
- Ваш лечащий врач может не помнить все особенности приема всех пероральных средств. Нет ничего зазорного, чтобы уточнить особенности приема вашего препарата. Спрашивать не только можно, но и нужно!
Какие существуют особенности приема внутрь отдельных противоопухолевых препаратов?
- Этопозид: внутрь, натощак (можно принимать, запивая стаканом апельсинового сока). Избегать действий, которые могут привести к травмам и кровотечениям (включая бритье).
- Метотрексат: избегать действий, которые могут привести к травмам и кровотечениям (включая бритье); избегать солнца.
- Винорелбин: внутрь, целиком, не разжевывая и не рассасывая во рту, запивая водой. В связи с наличием сорбита, винорелбин не следует использовать у больных с наследственной непереносимостью фруктозы.
- Тамоксифен: внутрь, не разжевывая, запивая водой. В начале лечения в течение 2 недель возможно увеличение мягкотканных образований и эритема пораженных областей.
- Анастрозол, Летрозол: внутрь целиком, в одно и то же время, запивая водой. Применяется только в постменопаузе или у пациенток с овариальной супрессией.
- Эксеместан: внутрь, желательно после еды. Применяется только в постменопаузе или у пациенток с овариальной супрессией.
- Сунитиниб: внутрь, независимо от приема пищи. Может наблюдаться изменение окраски кожи вследствие наличия в препарате желтого красителя.
- Акситиниб: внутрь целиком, запивая стаканом воды, вне зависимости от приема пищи;
- Сорафениб: внутрь, в промежутках между приемами пищи или вместе с пищей, содержащей низкое или умеренное количество жира, запивая стаканом воды.
- Регорафениб: внутрь целиком, запивая водой, 1 раз в сутки в одно и то же время после приема пищи, содержащей низкое ( <30%) количество жиров.
- Пазопаниб: внутрь целиком 1 раз в сутки, не менее чем за 1 час до или через 2 часа после приема пищи.
- Гефитиниб: внутрь, независимо от приема пищи, 1 раз в сутки. Можно также растворить (в течение 15 минут) в 100 мл питьевой (негазированной) воды и вводить внутрь через назогастральный зонд. N.B! В составе препарата - лактоза (необходимо учитывать непереносимость)!
- Эрлотиниб: внутрь, 1 раз в сутки, не менее чем за 1 час или через 2 часа после приема пищи. Курение снижает концентрацию эрлотиниба в плазме крови на 50-60%
- Афатиниб: внутрь, натощак, не менее чем за 1 ч до приема пищи или спустя 3 часа после приема пищи.
- Осимертиниб: внутрь целиком, 1 раз в сутки, в одно и то же время вне зависимости от приема пищи. Можно растворить в 15 мл питьевой (негазированной) воды и вводить через назогастральный зонд
- Кризотиниб: Внутрь целиком, вне зависимости от приема пищи. Избегать употребления грейпфрута и грейпфрутового сока
- Олапариб (табл., капс.): Внутрь целиком, через 1 час после или за 2 часа до приема пищи. B! Дозы таблеток и капсул не взаимозаменяемы!
- Палбоциклиб: внутрь целиком вместе с пищей в одно и то же время. Избегать грейпфрута или грейпфрутового сока, а также препаратов зверобоя.
- Рибоциклиб: внутрь целиком вне зависимости от приема пищи в одно и то же время.
- Лапатиниб: внутрь, за 1 час до или через 1 час после еды. Суточную дозу нельзя делить на приемы.
- Дабрафениб: внутрь 2 раза в сутки в одно и то же время через 1 час после или за 2 часа до приема пищи. Может быть повышение уровня глюкозы, что потребует изменения доз препаратов для лечения сахарного диабета.
- Траметиниб: внутрь 1 раз в сутки в одно и то же время, через 1 час после или за 2 часа до приема пищи.
- Вемурафениб: внутрь целиком 2 раза в сутки, вне зависимости от приема пищи, однако следует воздержаться от длительного приема обеих доз натощак.
- Кобиметиниб: внутрь целиком 1 раз в сутки, вне зависимости от приема пищи.
- Клодроновая кислота: внутрь. Суточная доза 1600 мг однократно утром натощак (за 1 час до еды), запивая стаканом воды (если >1600 мг, то в 2 приема). Нельзя принимать вместе с молоком, пищей и препаратами, содержащими двухвалентные катионы (кальций, препараты железа, антациды). Избегать стоматологических вмешательств во время приема клодроновой кислоты. До начала приема клодроновой кислоты следует санировать полость рта.
Что делать в случае пропуска приема таблетки(-ок)?
- Сообщить об этом вашему лечащему врачу
- В следующий прием НИКОГДА не принимайте дополнительно пропущенную дозу! *
* За исключением некоторых случаев. Необходимо ознакомиться с инструкцией к препарату.
Как не забыть принять противоопухолевые лекарства?
- Принимать таблетки в одно и то же время и при одних и тех же обстоятельствах каждый день.
- Поставьте напоминание на своем смартфоне.
- В путешествие возьмите с собой достаточно таблеток на случай непредвиденных задержек.
- Ведите дневник с информацией о вашем самочувствии. Держите дневник на видном месте.
- Просите родственников напоминать о приеме лекарств.
Что делать, если выпил двойную (и более) дозу?
- Немедленно сообщить об этом лечащему врачу.
- Тщательно следить за состоянием своего здоровья (вести дневник).
- В некоторых случаях потребуются срочные мероприятия (например, введение кальция фолината при передозировке метотрексата в течение первого часа).
Мне дали пачку таблеток - я могу просто пить таблетки и больше ничего не делать?
Нет, при каждом из препаратов требуется периодически выполнять обследования с целью выявления возможных осложнений лечения. Примеры:
Что такое химиотерапия: первый сеанс
Как проходит первая химиотерапия — один из самых частых вопросов пациентов и их близких. Химиотерапия (ХТ) пугает не меньше самого злокачественного процесса и добавляет негатива восприятию своего заболевания. Боятся осложнений, но главное — в неизвестности непосредственной реакции и отдалённого результата — вдруг мучения окажутся напрасными.
Как проходит химиотерапия?
Химиотерапия предполагает использование цитостатиков, но на практике так называют любое противоопухолевое лекарственное лечение, в том числе использование таргетных и иммуно-онкологических препаратов. Что логично, поскольку они объединяются в схемы с цитостатиками, дополняют курсы химиотерапии и приходят на смену цитостатическим средствам при неэффективности.

Выбор схемы и входящих в неё лекарств обусловлен локализацией злокачественного процесса, так по-разному лечат рак молочной железы и карциному желудка. Лекарства подбираются по морфологической структуре опухоли, то есть плоскоклеточный рак и аденокарцинома легкого неодинаково чувствительны к лекарственным препаратам.
Способы проведения курса химиотерапии многообразны:
- внутривенные инфузии — обычно их называют «укол в вену», когда препарат шприцем вводится в вену в небольшом разведении;
- внутриартериальные инфузии от внутривенных отличаются не только сосудом, но и большей технической сложностью введения в артерию с высоким давлением, как правило, таким способом в определенную анатомическую область доставляются очень высокие дозы химиопрепарата;
- внутривенные капельные вливания предполагают введение препарата в кровеносное русло в хорошем разведении и с небольшой скоростью, один из современных вариантов — многочасовое и даже многосуточное впрыскивание лекарственного средства специальной помпой — инфузоматом;
- внутриполостная химиотерапия — впрыскивание цитостатика внутрь плевральной и брюшной полости, в том числе длительное орошение полости во время операции на фоне гипертермии;
- внутрипузырные инстилляции — вариант внутриполостной ХТ, когда лекарство вводится в мочевой пузырь;
- подкожное и внутримышечное введения применяются очень редко из-за местного раздражающего действия, присущего большинству цитостатиков;
- локальная аппликация — цитостатик в виде мази;
- пероральная химиотерапия — идеальный способ лечения, когда принимаются таблетки или капсулы, к сожалению, основная масса химиопрепаратов выпускается в порошках для растворения или готовыми растворами.
Обязательное условие для начала любой химиотерапии у любого больного — морфологическая верификация злокачественного процесса, то есть полученный при биопсии или во время операции кусочек опухоли изучен под микроскопом, заболевание классифицировано и доказано, что это точно злокачественный процесс. В сомнительных случаях, когда нет 100% уверенности, что это рак, саркома, меланома, лейкоз и так далее, химиотерапию проводить нельзя.
К первому курсу химиотерапии пациент подходит полностью обследованным, если планируется предоперационная или неоадъювантная ХТ, или уже получившим на первом этапе радикальное лечение в виде операции, по необходимости дополняемой профилактической или адъювантной ХТ.
Обследованным пациент будет считаться, когда:
- определены все зоны локализации опухолевого процесса и размеры узлов;
- выяснено состояние сердечно-сосудистой и дыхательной систем, ЦНС и ЖКТ — есть понимание объективного состояния организма, объем функций и ограничений со стороны других органов позволяет провести терапию определенной комбинации и длительности;
- в биохимическом и клиническом анализах крови, анализе мочи все показатели в норме, то есть нет доказательств недостаточности функциональных возможностей и скрыто протекающих патологических состояний;
- при некоторых злокачественных процессах необходима информация о концентрации опухолевых маркёров, что в дальнейшем позволит оценить эффективность терапии.
Поскольку многие цитостатики негативно влияют на кроветворение, анализ крови на лейкоциты и тромбоциты должен быть «первой свежести» — не позже недели.
Режим и время приема препаратов
Каждое лекарственное средство имеет собственный профиль фармакологического действия, требует определенного способа введения в кровь больного и оптимальную дозу на введение.
Разовая дозировка рассчитывается на килограмм веса больного или на кожную поверхность. Для набора достаточной цикловой дозы какое-то лекарство необходимо принимать несколько недель каждый день, что-то требуется вводить раз в неделю, а что-то можно ввести один раз на целых три недели.
Продолжительность введения химиопрепарата обусловлена непосредственными токсическими реакциями или лучшим результатом воздействия на злокачественные клетки. Например, трёхчасовая капельница с производным платины «смягчает» повреждение почек, а часовое введение гемцитабина показало максимальную эффективность в сравнении с инъекцией шприцем.

Длительность курса химиотерапии
Курс ХТ состоит их нескольких циклов, где цикл предполагает введение определенной комбинации препаратов — схемы в определенной дозе и с определенными интервалами, если необходим набор суммарной дозы. Так циклом считается 14-дневный пероральный прием капецитабина, пять введений раз в неделю винорельбина или введение за один день сразу двух препаратов — паклитаксела и доксорубицина.
Несколько таких циклов составляют курс или одну линию химиотерапии. Оптимальная длительность курса с числом циклов определяется в клинических исследованиях, где учитывается не только процент наилучших результатов, но и накопление токсичности — кумулятивный эффект.
Количество курсов химиотерапии и побочные эффекты
Курсы проводятся пока можно надеяться на уменьшение злокачественной опухоли. Как уменьшение опухоли, стабилизация ракового процесса тоже свидетельствует о пользе лечения и говорит об уничтожении популяции чувствительных к цитостатикам клеток. Прогрессирование процесса на фоне лечения свидетельство неэффективности ХТ и необходимости смены комбинации лекарств.
Стандартная комбинация, предлагаемая для первого применения, самая результативная при данной структуре рака и не самая агрессивная. Второй рекомендуется менее эффективная схема лечения, третьей — ещё менее полезная. Для большинства злокачественных процессов разработано три линии лечения, то есть с той или иной пользой можно провести три курса ХТ из нескольких циклов, дальнейшая терапия малоперспективна и точно обещает побочные эффекты, но не позитивный результат.
Когда на первых циклах при нескольких линиях химиотерапии опухоль уменьшалась, а потом возобновляла рост, клетки можно считать чувствительными и есть основания для использования четвёртой-пятой линий.
Ограничить непрерывную смену линий могут побочные эффекты и истощение ресурсов организма по восстановлению химиотерапевтических повреждений. Так с каждым циклом ХТ всё дольше восстанавливается кроветворение, всё выраженнее повреждение почек и периферических нервов, всё труднее печени бороться с интоксикацией.
Только всех пугающая тошнота и рвота сегодня вполне предотвратимый побочный эффект, с которым успешно справляются специалисты нашей клиники, потому что применяют не только сильные противорвотные, но и целую программу подготовки и сопровождения химиотерапии.
Можно ли прерывать курс?
Прерывать курс нежелательно, для лучшего результата необходимо соблюдать разовые и суммарную дозы и интервалы между введениями. Тем не менее, приходится прекращать лечение при опасных для жизни осложнениях, в том числе снижении ниже критического уровня лейкоцитов и тромбоцитов, развитии стоматита и проявляющегося поносами лекарственного колита.
Перерыв между курсами химиотерапии
Перерыв между курсами зависит от достигнутого результата — ремиссии заболевания. Частичная ремиссия — когда клетки опухоли находятся в спящем режиме, полная — полностью уничтожены все проявления болезни. Свободный от проявлений злокачественной опухоли интервал может занять месяцы и годы, период ремиссии очень индивидуален и предсказать его длительность невозможно.
1-й курс химиотерапии
Первый курс обязательно завершится, и совершенно точно, что пройдет он не так, как предполагал пациент. Химиопрепараты убивают не только раковые клетки, но и нормальные, поэтому невозможно предугадать переносимость, гораздо важнее достигнутый в результате лечения результат. Переносимость следующего цикла будет отличаться от предыдущего, потому что на спектре и частоте осложнений сказывается состояние здоровья и настроение, погода и качество препаратов, время года и состояние пищеварения, и ещё много чего.
Клинические исследования выявили оптимальный курс для начала лечения, но это не означает, что у конкретного пациента первая химиотерапия будет самой эффективной, вполне возможно, что второй или даже третий курс дадут лучшие результаты.
Чувствительность злокачественных клеток к лекарствам очень индивидуальна, предсказать её помогает анализ, который выполняют в «Евроонко». Известна вероятность развития осложнений, но какими они будут и будут ли вообще, сказать невозможно. Тем не менее, в «Евроонко» для каждого пациента рассчитывается индивидуальная программа сопровождения химиотерапии, помогающая перенести лечение с наименьшими потерями для здоровья при максимально возможном результате.
Читайте также:
- Воздействия жизненных перемен в пожилом возрасте
- Диагностика псевдоаневризмы головного мозга по КТ, МРТ, аневризме
- Макролиды и кетолиды для лечения заболеваний уха, горла, носа
- Баланопостит
- Лапароскопия. Показания к лапароскопии. Показания к экстренной диагностической лапароскопии. Противопоказания к лапароскопии. Абсолютные и относительные противопоказания к лапароскопии.

